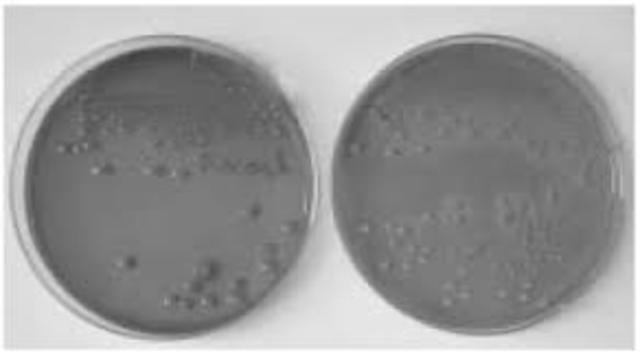
Como obtener cultivos puros sobre medio solido

-
Hans Janssen (1590-1608) desarrolla el primer microscopio compuesto.
-
Robert Hooke marca el inicio de la teoria celular
-
Utiliza unos botes de cristal con trozos de carne, dichos botes los tapa con unas gasas que permiten el paso del aire pero de nada más, entonces no se generan "animáculos" en estos trozos de carne. La solución está en las larvas que son depositadas por moscas que se posaban en la carne, en los botes sin tapar, y hacían posible la aparición de esos "animáculos".
-
Van Leeuwenhoek fue el primero en observar los microorganismos vivos a traves de las lentes de aumento con las cuales construyo mas de 400 microscopios
-
Fabricó la primera lente lo suficientemente poderosa como para observar a los organismos unicelulares. Utilizó una lente convexa y colocó al objeto dentro de la distancia focal.
Mejoras en la fabricación de microscopios, precursor de la biología celular y la microbiología -
fue realizada por Anton van Leeuwenhoek realizó la primera observación microbiológica registrada de "animáculos", como van Leeuwenhoek los llamó. Este arreglo produce una imagen virtual o aparente muy amplificada; con este rudimentario pero ingenioso microscopio logró observar muchos "pequeños animalillos". Éstos incluían protozoarios, tanto de vida libre como parásitos de las vísceras de algunos animales; también logró observar hongos filamentosos y corpúsculos globulares que ahora conocemos c
-
estableció los fundamentos para el esquema moderno de la nomenclatura binomial. Se le considera el fundador de la moderna taxonomía, y también se le reconoce como uno de los padres de la ecología.
-
El calentamiento puede evitar la aparición de los animáculos, pero cuando aparecían era por el aire que entraba, por lo que se dedujo que estaban en el aire.
-
Eugenio Espejo (1747-1795) publicó importantes trabajos de medicina, como las Reflexiones acerca de la viruela (1785), el cual se convertiría en el primer texto científico que refería la existencia de microorganismos
-
Edward Jenner introdujo la primera vacuna segura contra el virus de la viruela.
-
Se introdujo el termino bacteria hasta el año de 1828
-
descubrimiento de los virus y el desarrollo de técnicas de cultivo
-
había organismos que podían ser causantes de la enfermedad. Carbunco y Antrax son enfermedades con las que estudió Rayer.
Los organismos afectados tenían un determinado microorganismos en la sangre. -
Anton de bary, conocido como el padre de la fitopatologia y fundador de la micologia al descubrir enfermedades micoticas producidas por hongos y bacterias sobre las plantas.
Es considerado fundador del estudio de las enfermedades vegetales o fitopatología -
Pasteur descubre que los microorganismos llamados levaduras convertian los azucares en alcohol en ausencia de aire.
-
pasando un tubo con aire y un algodón en el medio impregnado de eter. Lo miraba al microscopio y veía organismos, pero en cambio cuando lo hacía con aire caliente no veía absolutamente nada.
-
La academia de ciencias desaprueba la teoria de Pasteur.
-
Cohn fue también el primero en formular un esquema para la clasificación taxonómica de las bacterias.
-
Robert Koch invento los metodos sobre medios solidos para obtener cultivos bacterianos puros.
-
Koch descubre el agente causal de la colera al cultivar y examinar en los intestinos de todos los enfermos de colera la bacteria Vibrio cholerae
-
Louis Pasteur puso a punto una vacuna contra la rabia.
-
Fritz Schaudinn y Erich Hoffmann demuestran que el Treponema pálidum es el agente productor de la sífilis.
-
Walter Reed confirma que la fiebre amarilla es transmitida por mosquitos, hecho previamente observado por Carlos Finlay en 1881
-
Howard Taylor Ricketts demuestra que la fiebre de las Montañas Rocosas es transmitida por garrapatas, y aisló el microorganismo causante de la enfermedad (que él llamó rickettsia). Falleció por esa enfermedad.
-
Francis Peyton Rous descubre el virus (retrovirus) que produce tumores (sarcomas) en pollos.
-
Frederick Griffith lleva a cabo el descubrimiento de la transformación bacteriana.
-
Fleming, Florey y Chain ganadores del premio nobel en medicina y fisiologia por el descubirmiento de la penicilina y sus efectos curativos en varias enfermedades infecciosas.
-
Frits Zernike desarrolla el microscopio de contraste de fases que permite ver microorganismos vivos.
-
Helmut Ruska inventa el microscopio electrónico.
-
Robert Gallo y Luc Montagnier llevan a cabo el aislamiento e identificación del virus del sida.
Looking for a timeline maker?
Create timelines for projects, roadmaps, history, lessons, legal cases, and stories with Timetoast. Timetoast is a timeline maker for work, school, research, and stories.